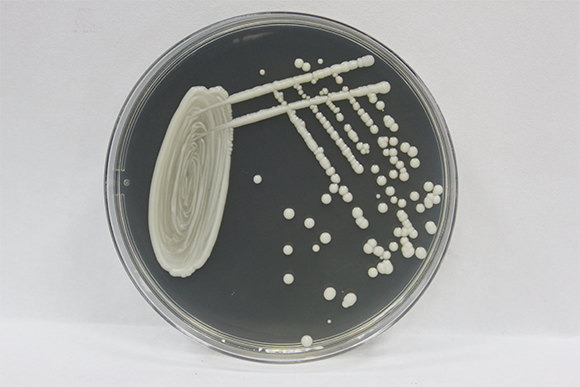

מגפה מסתורית שמקורה בפטרייה מוטנטית מתפשטת במהירות ומדביקה את רוב אוכלוסיית העולם. הפטרייה משתלטת על מוחם של קורבנותיה והופכת אותם למעין זומבים שכל רצונם להדביק אחרים. מציאות דמיונית זו מתוארת בסדרת הטלוויזיה המצליחה “האחרונים מבינינו” (The Last of Us) של חברת HBO, המבוססת על משחק וידאו של חברת Naughty Dog שיצא בשנת 2013 בתור משחק לקונסולת פלייסטיישן והתפשט בסערה בעולם הגיימינג.
העלילה דמיונית לחלוטין ובמציאות איננו עומדים על סף אחרית הימים בגלל פטרייה, אבל היא נוצרה בהשראת פטריות אמיתיות מסוג אופיוקורדיספס (Ophiocordyceps) המכונות “פטריות זומבי”. מדובר בפטריות טפיליות שפולשות לתוך גופם של חרקים ופרוקי רגליים אחרים ובמקרים רבים משתלטות עליהם. הפטריות משחררות לגוף החרקים כימיקלים שמשפיעים על מוחם ושולטים על התנהגותם של הקורבנות חסרי המזל. כתוצאה מכך החרקים הופכים ליצורים דמויי זומבי הפועלים ומתנהגים בצורה שמגבירה את סיכויי הפטרייה להתרבות ולהתפשט. לאחר שניזונה מגופו של הקורבן והתפתחה בתוכו, הפטרייה גורמות לו לנדוד למקום שיקל עליה להדביק אחרים. במיקום הזה היא הורגת אותו, פורצת מתוך גופו, צומחת החוצה ומפזרת נבגים מידבקים, שהם גופיפי הרבייה של הפטרייה.
למרבה המזל השתלטות כזו אינה מסכנת בני אדם או מאיימת עליהם, ואין סכנה לאפוקליפסת זומבים כפי שמתוארת בסדרה ובמשחק. עם זאת, מדענים מזהירים כי פטריות הן איום שהולך ומתעצם. פטריות שחיות כיום בטבע ואינן מסוכנות בני אדם עלולות, עם התחממות כדור הארץ, לעבור שינויים גנטיים ולהסתגל לתנאי הגוף האנושי, להדביק אותו ואולי גם להפוך לאלימות יותר. כפי שהזהירה הדמות שמגלם ג’ון האנה, ד”ר נוימן, בפרק הראשון של “האחרונים מבינינו”. במצב כזה אנו עלולים לעמוד בפני איום של ממש.

מדביקות חרקים ושולטות בהם, אך לא בני אדם. גוף הפרי של פטריית אופיוקורדיספס בוקע מראש נמלה | צילום: Hyde Peranitti, Shutterstock
פטריות הן לא רק שמפיניון
פטריות הן בין צורות החיים הנפוצות ביותר על פני כדור הארץ וכוללות לפי חלק מההערכות כ-12 מיליון מינים. רק חלק קטן מתוכן מדביק בני אדם. עם זאת מדי שנה מתרחשים ברחבי העולם מעל 150 מיליון מקרים חמורים של הדבקה פטרייתית וכ-1.7 מיליון אנשים מתים מהם, יותר משחפת וממלריה.
למרות השכיחות הרבה של זיהומים פטרייתיים רשויות בריאות הציבור מזניחות את הטיפול בהם, בוודאי בהשוואה לטיפול בחיידקים או בנגיפים. רוב הזיהומים הפטרייתיים אינם מאיימים על אנשים בריאים בזכות מערכת החיסון. הזיהומים החמורים מתרחשים בעיקר אצל אנשים שסובלים ממערכת חיסון מוחלשת, כתוצאה מבעיות בריאות כמו סוכרת, איידס, וסוגי סרטן מסוימים, או עקב טיפולים המדכאים את מערכת החיסון, כגון טיפולים למניעת דחיית שתל לאחר השתלת איברים, טיפולי כימותרפיה וטיפולים לאסתמה.
רוב הפטריות אינן מסוגלות לחיות, להתרבות ולהתבסס בטמפרטורה הגבוהה (יחסית לסביבה) של גוף האדם. יתרה מזאת, כאשר אדם נדבק במזהם, כגון חיידק, נגיף או פטרייה, חום הגוף עולה עוד יותר ומשבש את הניסיונות של הפולש להתפתח. אבל מומחים רבים חוששים כי מנגנון הגנה זה עומד לאבד מיעילותו. הם סבורים כי ככל שטמפרטורת הסביבה עולה עקב משבר האקלים, יופיעו פטריות שהסתגלו לטמפרטורות גבוהות יותר, ולכן יוכלו לפרוץ את ההגנה שטמפרטורת הגוף מספקת לגוף האדם, ולהפוך למסוכנות יותר.
ככל שטמפרטורת הסביבה עולה עקב משבר האקלים, יופיעו פטריות שיכולות לפרוץ את ההגנה של גוף האדם. פטריית קנדידה על צלחת פטרי | צילום: Rejo Jacob Joseph, Shutterstock
רק לאחרונה יצא איגוד רופאי בריאות הציבור בישראל בקריאה שייתכן שתרחיש כזה מתרחש לנגד עינינו כבר היום, בשל התפשטות מדאיגה של הפטרייה הקטלנית קנדידה אוריס (Candida auris), שעלולה לגרום לזיהום פולשני ומוות. הפטרייה התגלתה לראשונה אצל בני אדם רק ב-2009, באוזנה של אישה ביפן. אך מקרה ההדבקה הידוע הראשון התרחש כבר ב-1996, כפי שגילה ניתוח זני קנדידה שבודדו מדמה של ילדה בקוראה הדרומית. מדענים מציעים את האפשרות שההתחממות הגלובלית גרמה לפטרייה שהייתה מותאמת לטמפרטורת הסביבה להסתגל לחום גבוה יותר ולהתפשט גם בבני אדם. כיום הפטרייה מידבקת יותר, אלימה יותר ועמידה יותר לתרופות נגדה. במגמה לעצור את התפשטותה בבתי חולים הכניס ה-CDC בשנת 2016 את הפטרייה לרשימת הפטריות והחיידקים המוגדרים כ”איומים דחופים”.
לרוע המזל, משנת 2021 יש התפשטות נרחבת ומדאיגה של קנדידה אוריס במספר בתי חולים בארץ, וחלקם אף נאלצו לסגור את המחלקות הנגועות לפרקי זמן מסוימים. מומחים מציינים כי 50 אחוזים מתוך החולים מוחלשי החיסון שנדבקים בקנדידה – מתים בתוך 90 יום. בדרך כלל מדובר במעשנים כבדים, חולי סוכרת, חולים במחלות אוטואימוניות המטופלים בסטרואידים ותינוקות. הם מאשימים את משרד הבריאות בכך שלא נענה לאזהרות שפורסמו כבר ב-2016, ולא פעל בזמן כדי לעצור את ההתפשטות המסוכנת.
חום מגביר את איום הפטריות
במחקר שהתפרסם בכתב העת PNAS צוות חוקרים מאוניברסיטת דיוק בארצות הברית מראה כיצד עלייה בטמפרטורת הסביבה יכולה לגרום לפטריות לפתח עמידות לטמפרטורת הגוף ולהפוך למסוכנות יותר. הם גידלו במעבדה פטרייה מסוג קריפטוקוקוס (Cryptococcus) שגורמת לדלקת ריאות או לדלקת קרום המוח אצל בני אדם. כדי לבדוק את השפעת טמפרטורת הגידול על הפטרייה, הם גידלו פטריות למשך 800 דורות בטמפרטורה של 30 מעלות צלזיוס וגם ב-37 מעלות צלזיוס, שנחשבת כטמפרטורת הגוף. לאחר מכן הם קבעו את הרצף של מקטעי DNA ארוכים בגנום הפטרייה ועקבו אחר שינויים שחלו בו. הם התמקדו בעיקר בשלושה מקטעים המכונים טרנספוזונים או “רצפים קופצים”. אלו מקטעים ניידים שבאופן טבעי עוברים ממקום למקום על פני הגנום, ואשר כניסתם לאזורים שונים בגנום עשויה להשפיע על אופן הפעולה של גֵּנִים אחרים. כאשר גידלו את הפטרייה בטמפרטורה של 37 מעלות צלזיוס, שלושת המקטעים “קפצו” בתדירות גבוהה פי חמישה בהשוואה לפטריות שגדלו ב-30 מעלות. התוצאות מראות כי עקת חום, כלומר מצב של לחץ הנובע מחום, מעוררת ניידות של טרנספוזונים ומגבירה לאין ערוך היווצרות של שינויים גנטיים, כלומר מוטציות. אחד מהטרנספוזונים שנבדקו קפץ אל אזורים ב-DNA שנמצאים בין גֵּנִים ושאינם משפיעים על רצף החלבון שנוצר על פי הגֵּן, אך יכולים להשפיע על החלבון הנוצר בדרכים אחרות, למשל על כמותו. טרנספוזון אחר חדר לעיתים קרובות לתוך רצף של הגֵּן, בדרך שעלולה לשבש את פעילותו התקינה של החלבון שנוצר לפי ההוראות בגן, ואולי אף להוביל לעמידות לתרופות. לטרנספוזון השלישי הייתה נטייה להיכנס ליד או בתוך רצפים הנמצאים בקצות הכרומוזומים וקרויים טלומרים. השפעתו לא ברורה במלואה.

גורמת ליותר ויותר מקרים של מחלות מסכנות חיים. צילום מיקרוסקופ של הפטרייה Cryptococcus neoformans | מקור: CDC/ Dr. Leanor Haley
החוקרים ראו כי התנועה המוגברת של המקטעים הניידים קורית לא רק בפטריות שגדלו במעבדה, אלא גם בתוך עכברים שהודבקו בפטרייה. הם הופתעו לגלות כי כבר בתוך 10 ימים מרגע הדבקת העכברים החלה תנועה של שלושת הטרנספוזונים. נראה כי כאשר הפטרייה עומדת בפני איום על הישרדותה, כמו פעילות מערכת החיסון נגדה וגורמי לחץ נוספים, הטרנספוזונים הופכים לפעילים יותר.
אם כן, החוקרים מזהירים כי ההתחממות הגלובלית יכולה לזרז תהליכים שמעודדים היווצרות מוטציות בפטרייה, ולכך יש השפעה על האבולוציה שלה. ככל שכדור הארץ מתחמם, טרנספוזונים עשויים להפוך לניידים יותר ולהגביר את שכיחות השינויים בגנום. בגלל הברירה הטבעית, שינויים שיגבירו את עמידות הפטריות לחום יתפשטו באוכלוסייה, עד להופעת פטריות שיכולות לשרוד בטמפרטרת הגוף, להתבסס בתוכו ולהפוך למידבקות ואלימות יותר, וייתכן שגם יהיו עמידות יותר לתרופות. בעקבות זאת, פטריות שבעבר לא הזיקו לבני האדם עלולות להפוך למסוכנות.
טמפרטורת הגוף יורדת בהדרגה?
בעוד שהתחממות כדור הארץ עלולה לגרום לפטריות להסתגל לטמפרטורות גבוהות יותר, על פי קבוצת חוקרים מאוניברסיטת סטנפורד, טמפרטורת הגוף של האדם יורדת בהדרגה. אם זה נכון, הפער בין הטמפרטורה האידיאלית לפטריות לבין טמפרטורת הגוף הולך ומצטמצם.
החוקרים הבחינו כי לאורך 160 השנים האחרונות טמפרטורת הגוף הממוצעת של האדם ירדה מעט אך בהתמדה. מחקר שפורסם ב-2020 בכתב העת eLife בדק נתונים שנאספו בין השנים 1860 ל-2017 ומצא כי טמפרטורת הגוף של גברים ונשים כאחד ירדה. החוקרים מצאו כי טמפרטורת הגוף של גברים שנולדו בשנות ה-2000 הייתה נמוכה בממוצע ב-0.59 מעלות צלזיוס מזו של גברים שנולדו בתחילת המאה ה-19 ובאופן עקבי יש ירידה של 0.03 מעלות צלזיוס בכל עשור. באופן דומה, טמפרטורת הגוף של נשים ירדה ב-0.32 מעלות צלזיוס. החוקרים סבורים כי הנתונים שבהם השתמשו במחקר משקפים את המציאות ואינם נובעים מהבדלים במכשירי המדידה או בשיטות המדידה. עם זאת, ייתכן שטמפרטורת הגוף תמיד הייתה נמוכה יותר מהרמה המקובלת של 37 מעלות צלזיוס, ולא בטוח עד כמה אפשר להסתמך על מדידות החום שנעשו בתקופת מלחמת האזרחים האמריקנית.
מחקר אחר, שבדק אוכלוסייה של חקלאים-ציידים-לקטים בבוליביה, מצא גם הוא ירידה בטמפרטורת הגוף הממוצעת מ-37 מעלות צלזיוס בתחילת המאה ה-21, ל-36.5 מעלות ב-2018. החוקרים סבורים שהירידה קשורה בין היתר לשינוי בתזונה ובאורח החיים, ירידה בהידבקות בטפילים, גישה לתרופות נוגדות דלקת ושימוש באנטיביוטיקה. אכן, מחקר שפורסם לאחרונה משער כי חיידקי המיקרוביום של המעי מעורבים בוויסות טמפרטורת הגוף במצבי בריאות וחולי.
אם כך, לא רק שהסביבה מתחממת, אלא נראה שאנו מתקררים. שני תהליכים אלו מצמצמים את הבדלי הטמפרטורות ועשויים להגדיל את האיום והסיכון של מחלות פטרייתיות באדם.

לא יגרמו לאפוקליפסת זומבים, אך פטריות עלולות לגרום למשבר בריאותי חמור. תמונה מתוך הסדרה “האחרונים שבינינו” | מקור: Hamara, Shutterstock
קריאת השכמה
בעוד שכיום חיידקים ונגיפים הם האחראים לעיקר דאגות הבריאות המתלוות לזיהומים, פטריות בדרך כלל לא מעוררות חששות כיוון שבאנשים בריאים הן גורמות לבעיות קלות בלבד. עם זאת, אם לא ננקוט אמצעים כדי לעצור את מגמת ההתפשטות של הפטריות ואת השינויים הגנטיים המהירים שחלים בהן בעקבות משבר האקלים, המצב עלול להשתנות, ואנו עלולים לעמוד בפני משבר בריאותי חמור. מגוון התרופות נגד פטריות מוגבל ולחלק מהתרופות כבר פטריות מסוימות פיתחו עמידות. אף שיש מספר חיסונים שנמצאים בניסויים קליניים, ה-FDA טרם אישר אפילו חיסון אחד נגד פטריות. פיתוח חיסונים יעילים נגד פטריות נחשב מאתגר יותר לעומת פיתוח חיסונים נגד חיידקים ונגיפים, בגלל הביולוגיה המורכבת שלהן וגיוון מיני הפטריות שעלולים לגרום לזיהומים.
אומנם המציאות עשויה להיראות מפחידה, אך עדיין לא הגיע הרגע להסתגר בבתים. השפעות שינויי האקלים על פטריות והפיכתן למזהמים שמאיימים על שלומם של אנשים בריאים הן תהליך מורכב הדורש כנראה יותר מעלייה בטמפרטורת הסביבה בלבד, ולכן לא סביר כי קיימת סכנה מיידית לשלום המין האנושי. עם זאת חשוב לחקור את הגורמים להתפשטות מחלות וזיהומים פטרייתיים, לפעול למניעתם ולהגדיל את מגוון הטיפולים והתרופות נגדם.